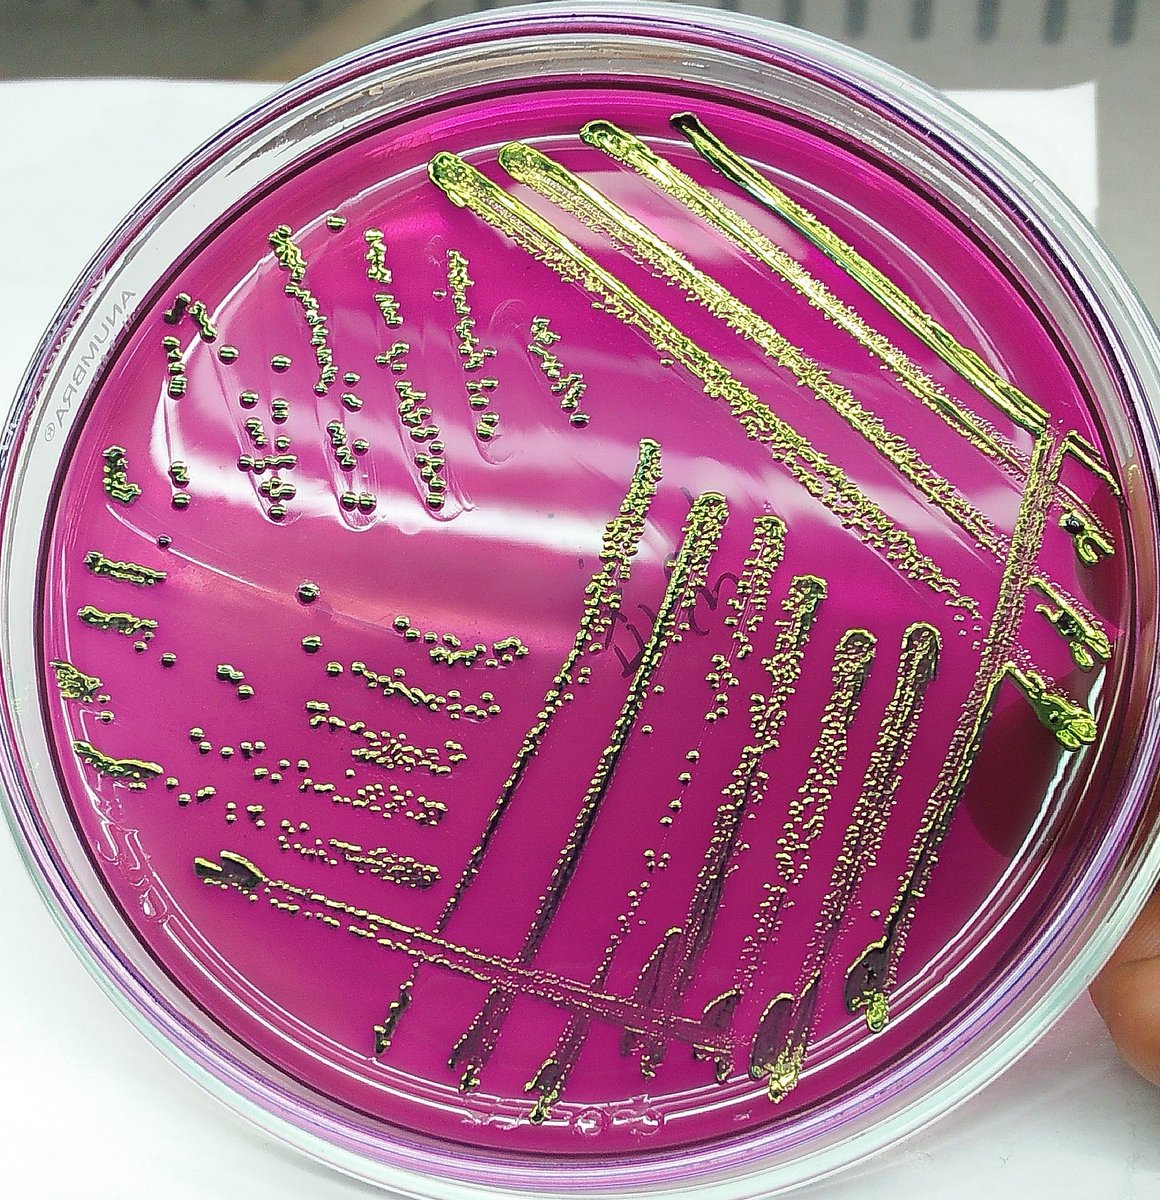
Prof. Dr. Md. Tanvir Rahman, FBAS tweet media

Arama Sonuçları: "#MTRLab"
15 sonuç
Hong Kong's #MTRLab invests in French #proptech #WeMaintain to power its #AsiaPacific #expansion💡 WeMaintain's tech optimizes costs and boosts #sustainability 🚀 This partnership accelerates #smartcity solutions in the region 🏢🌏
buff.ly/487aKDy

English

#NewsUpdate | MTR Lab, part of Hong Kong's railway, sees a chance to drive smart city growth in Asia-Pacific.
realtynxt.com/news/mtr-lab-i…
#RealtyNXT #MTRLab #WeMaintain #IoTTechnology #SmartCityDevelopment #AsiaPacificExpansion
English

@tanvirahman Congratulations sir, and the whole #mtrlab team🎉
English

#mtrlabbau #tanviramrlabbau #mtrlab
Molecular Detection and Antibiotyping of Multidrug-Resistant Salmonella Isolated from Houseflies in a Fish Market mdpi.com/553426 #mdpipathogens via @Pathogens_MDPI
English

昨日もワラーチで軽くランニング🏃♂️
脹脛の外側が両脚共に痛い…←今現在
あっ!有機ゲルマニウムバーム塗ろ👏
5分も経たぬ内に
「えっ⁈全然痛くないんやけど…」
100%天然由来の唯一無二のバーム✨
冗談抜きにほんまに凄いのでお勧めです!
#MTRLab
#Growith
#有機ゲルマニウム
MTR Method Lab®︎【公式】@MTRLab
MTR Method Lab™️が開発したコンディショニングブランド『Growith』 有機ゲルマニウム(アサイゲルマニウム)を最適量添加したバームはサポート選手たちにも愛用していただいています。 すぐに筋肉チューニングができない時の痛みや張りにしっかり擦り込んでみてください。 ddgrowith.jp/?pid=169114084
日本語


#MTRLab, a wholly owned subsidiary of #MTRCorporation, has launched a #strategicplatform that works together with like-minded partners to construct carbon-neutral smart communities.
ow.ly/M5cm50LAInY
#smartcommunities #launch
English

#MTRLab, a wholly owned subsidiary of #MTRCorporation, has launched a #strategicplatform that works together with like-minded partners to construct carbon-neutral smart communities.
ow.ly/7hK850LAIlH
#smartcommunities #launch
English

#MTRLab, a wholly owned subsidiary of #MTRCorporation, has appointed Michael T. B. Chan (pictured) as managing director with immediate effect.
ow.ly/YqxO50LnzPT
#managingdirector #technology #ecosystem
English

この映像が全てを物語ってる🤣
ゴール後は10秒くらい動けず、、
意識も朦朧としてました。
その後すぐに妻の作ってくれたお弁当をたらふく頂きました😋
@oneness888_369
ありがとう!!!
※汚れたのは沢で何度か転んだから😂
#戸隠
#戸隠トレイル
#MTRlab
#トレイルラン
工藤 和恵@医食同源Lab/量子波動Labメタトロン@oneness888_369
拳大 @Ken_Kudo211 トレイルラン in 戸隠✨🗻 絶好のトレラン日和!🌞 鮭玄米おにぎりもっと握ってもよかったなー! ランニング中はデーツとゲルマ+モリンガでエネルギー切れを防ぐとのこと😆 人が沢山の中堂々と仁王立ちは流石👯♂ キツいコースだけど自然を感じて楽しんでー!!!🌲🌈🎶
日本語

モントレイル戸隠20km
タイム→1:53:01
総合8位 29歳以下の部2位入賞🥈
累積標高980mのコースで、途中スキー場を登ったり・下ったりとタフなレースでした🏔
ラスト3kmでエネルギー切れを起こし、急な痙攣や幻覚が襲ってきましたが、ゴールできて本当によかった!
#戸隠
#戸隠トレイル
#MTRlab




日本語